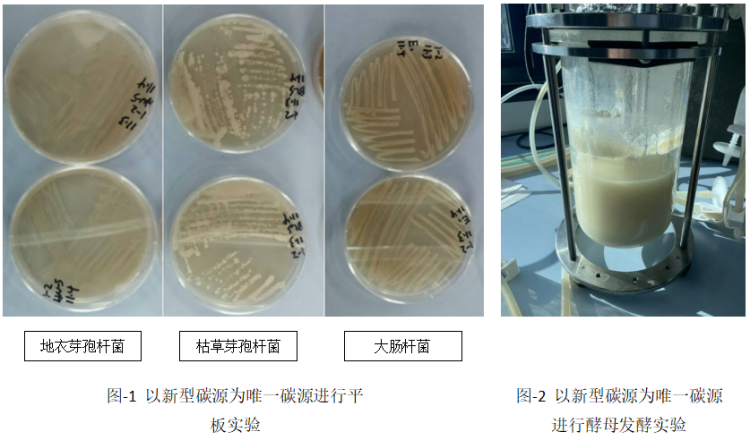
5.3.png

新型非粮碳源!青岛碧沃德突破10000升工业规模发酵运行
在当今发酵行业,碳源成本问题一直困扰着众多企业。传统碳源多依赖于粮食作物,不仅价格高昂、波动频繁,还面临着与民争粮的矛盾。与此同时,我国政策逐渐重视非粮生物基产业布局。
点击更多阅读:工信部又发文,事关非粮生物基材料产业!
突破非粮碳源的生物制造技术与相关企业受到行业高度关注。
其中,青岛碧沃德生物科技有限公司凭借多年生物柴油行业积累的技术与资源,突破常规,研发出滤膜碳源和合生甘霖碳源两种新型非粮碳源,为发酵行业带来全新变革。

传统发酵碳源主要来源于糖类,如葡萄糖等,价格居高不下且波动大。以PHA生产为例,仅碳源成本就占生产过程的40%-50%,每千克生产成本高达2-8美元。这不仅增加了企业的生产成本,也给粮食安全带来了潜在风险。
青岛碧沃德生物科技有限公司另辟蹊径,从油脂行业副产物中寻找解决方案。公司改进传统生产工艺,开发出滤膜碳源和合生甘霖碳源两种新型非粮碳源。这两种碳源以乙酸钠和丙三醇为主要成分,含有多种促进微生物生长的小分子有机酸、维生素等营养成分,适用多种微生物培养。它们不仅降低了对粮食作物的依赖,还降低了碳源成本,稳定供应市场,符合RED Ⅲ欧盟先进生物燃料原料要求,具有更高减排值。
经过平板试验与发酵罐发酵实验检测,枯草芽孢杆菌、地衣芽孢杆菌、大肠杆菌、解脂耶氏酵母等细菌与酵母在添加新型碳源的培养基中生长良好。青岛碧沃德公司还完成了10000L工业规模的发酵生产运行,充分证明了新型碳源的可靠性和高效性。
表:2种新型非粮碳源的适应菌种

青岛碧沃德生物科技有限公司提供多种合作模式,包括此类碳源利用的定向研发和委托加工,与合作伙伴共同探索发酵行业的新机遇。滤膜碳源和合生甘霖碳源的推出,不仅解决了传统碳源的困境,还为企业带来了新的成本优势和市场竞争力。选择青岛碧沃德,就是选择与未来同行,共同开启发酵行业的新篇章。

辛先生,13668882772
如对产品感兴趣,欢迎联系
▌参考信息:本文部分素材来自青岛碧沃德生物科技有限公司。由作者重新编写,系作者个人观点,本平台发布仅为了传达一种不同观点,不代表对该观点赞同或支持。如果有任何问题,请联系我们:15356747796(微信同号)
